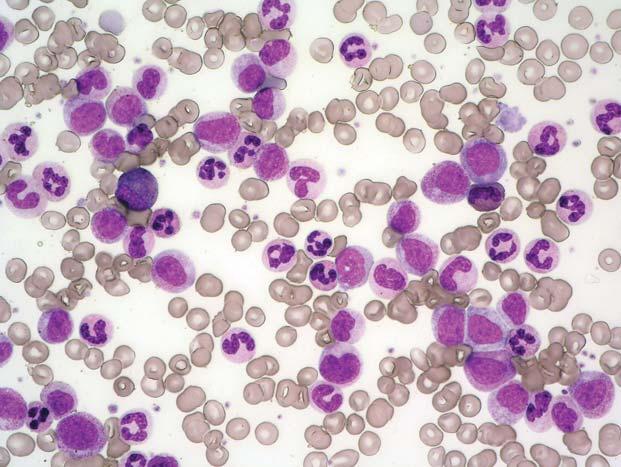
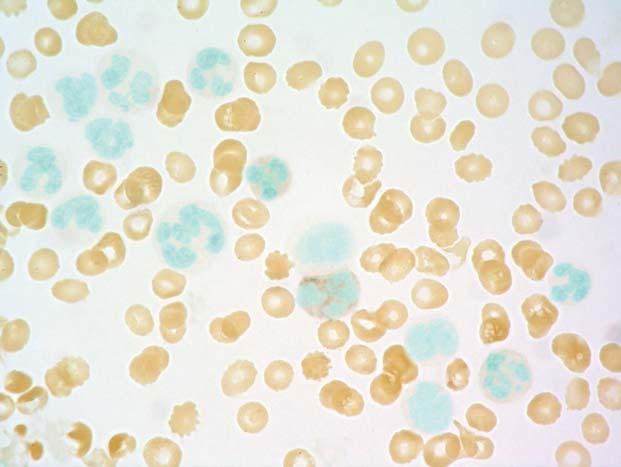
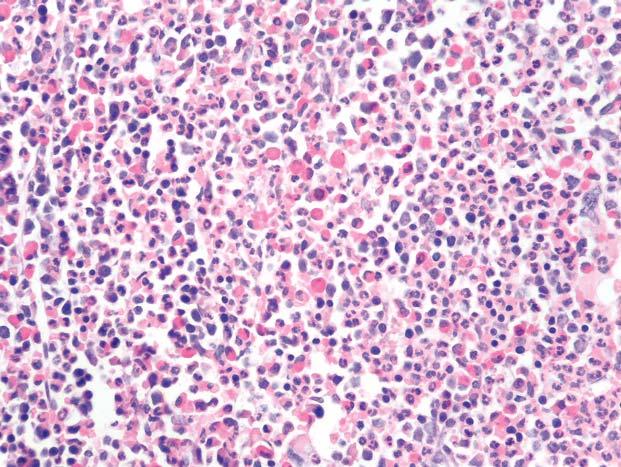
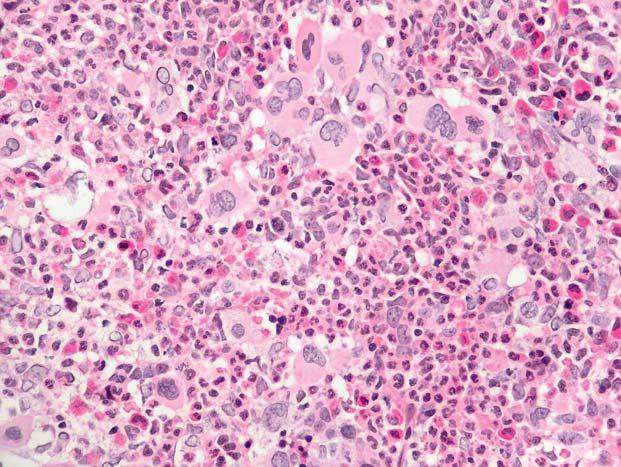
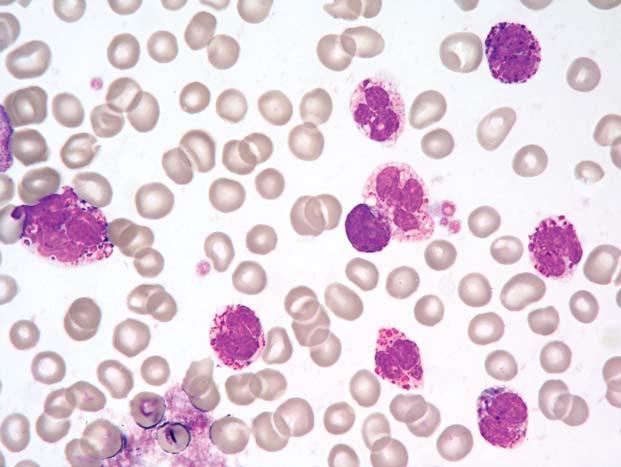
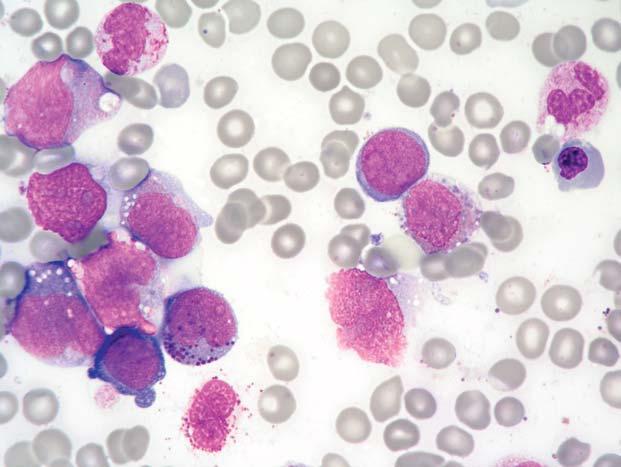
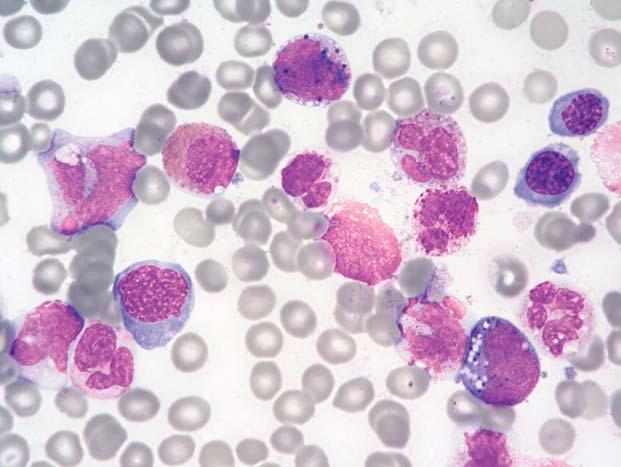

Obsah
Přehled použitých zkratek ...................................... VII Předmluvy recenzentů .............................................. XI Úvod ........................................................................ XIII
1 Chronická myeloproliferativní onemocnění .......... 1
1.1 Chronická myeloidní leukemie ............................... 1
1.2 Chronická neutrofilní leukemie .............................. 3
1.3 Chronická eozinofilní leukemie a hypereozinofilní syndrom .................................... 3
1.4 Polycythaemia vera ................................................. 5
1.5 Chronická idiopatická myelofibróza ....................... 6
1.6 Esenciální trombocytemie ....................................... 8
1.7 Chronické myeloproliferativní onemocnění neklasifikovatelné ................................................... 8
2 Myelodysplasticko-myeloproliferativní onemocnění ............................................................. 41
2.1 Chronická myelomonocytární leukemie ............... 41
2.2 Atypická chronická myeloidní leukemie .............. 42
2.3 Juvenilní myelomonocytární leukemie ................. 43
2.4 Myelodysplasticko-myeloproliferativní onemocnění neklasifikovatelné ............................. 43
3 Myelodysplastický syndrom .................................. 55
3.1 Refrakterní anemie ................................................ 60
3.2 Refrakterní anemie s prstenčitými sideroblasty .... 61
3.3 Refrakterní cytopenie s multilineární dysplazií .... 61
3.4 Refrakterní cytopenie s multilineární dysplazií a s prstenčitými sideroblasty ................................. 61
3.5 Refrakterní anemie s excesem blastů .................... 61
3.6 Myelodysplastický syndrom asociovaný s izolovanou del(5q) ............................................. 62
3.7 Myelodysplastický syndrom neklasifikovatelný ... 62
4 Akutní myeloidní leukemie ................................... 89
4.1 Akutní myeloidní leukemie s rekurentními genetickými abnormalitami .................................. 93
4.2 Akutní myeloidní leukemie s multilineární dysplazií ................................................................ 95
4.3 Postterapeutické akutní myeloidní leukemie a myelodysplastické syndromy ............................. 95
4.4 Akutní myeloidní leukemie jinak nekategorizované .................................................. 96
5 Akutní leukemie obtížně klasifikovatelné linie ........................................................................
5.1 Nediferencovaná akutní leukemie .......................
5.2 Bilineární akutní leukemie ..................................
5.3 Bifenotypová akutní leukemie ............................ 147
6 Malignity z prekurzorových B- a T-buněk ........ 155
6.1 Prekurzorová B-lymfoblastická leukemie/ lymfoblastický lymfom ....................................... 156
6.2 Prekurzorová T-lymfoblastická leukemie/ lymfoblastický lymfom ....................................... 158
7 Malignity ze zralých B-buněk ............................. 167
7.1 Chronická lymfatická leukemie/lymfom z malých lymfocytů ............................................. 169
7.2 B-prolymfocytární leukemie ............................... 170
7.3 Lymfoplazmocytární lymfom/Waldenströmova makroglobulinemie ............................................. 171
7.4 Splenický lymfom z B-buněk marginální zóny ... 171
7.5 Leukemie z vlasatých buněk ............................... 172
7.6 Malignity z plazmatických buněk ....................... 173
7.7 Extranodální lymfom z B-buněk marginální zóny ze slizniční lymfatické tkáně ...................... 176
7.8 Nodální lymfom z B-buněk marginální zóny ..... 176
7.9 Folikulární lymfom ............................................. 176
7.10 Lymfom z plášťových buněk ............................ 177
7.11 Difuzní velkobuněčný B-lymfom ..................... 178
7.12 Mediastinální velkobuněčný B-lymfom ........... 179
7.13 Intravaskulární velkobuněčný B-lymfom ......... 179
7.14 Primární exsudativní lymfom ........................... 179
7.15 Burkittův lymfom/leukemie .............................. 179
7.16 Lymfomatoidní granulomatóza ......................... 179
8 Malignity ze zralých T- a NK-buněk ..................
8.1 T-prolymfocytární leukemie ...............................
8.2 Leukemie z velkých granulárních T-lymfocytů ... 218
8.3 Agresivní leukemie z NK-buněk ........................ 218
8.4 Leukemie/lymfom z T-buněk dospělých (HTLV-1 pozitivní) ............................................
8.5 Extranodální lymfom z NK/T-buněk nazálního typu ..................................................................... 219
8.6 Intestinální lymfom z T-buněk, enteropatický typ ....................................................................... 219
8.7 Hepatosplenický T-lymfom ................................ 219
8.8 Panikulitický podkožní T-lymfom ......................
8.9 Blastický lymfom z NK-buněk ........................... 220
8.10 Mycosis fungoides a Sézaryho syndrom ........... 220
8.11 Primární kožní CD30 pozitivní T-lymfoproliferativní onemocnění .................... 220
8.12 Angioimunoblastický T-lymfom ...................... 220
8.13 Periferní T-lymfom nespecifikovaný ................ 221
8.14 Anaplastický velkobuněčný lymfom ................ 221
9 Hodgkinův lymfom .............................................. 233
9.1 Klasický Hodgkinův lymfom .............................. 233
9.2 Nodulární Hodgkinův lymfom s predominancí lymfocytů ............................................................ 234
10 Lymfoproliferativní onemocnění spojená s imunodeficity ................................................... 237
10.1 Lymfoproliferativní onemocnění spojená s primárními onemocněními imunity ................ 237
10.2 Lymfomy spojené s infekcí virem HIV ............ 237
10.3 Potransplantační lymfoproliferativní onemocnění ....................................................... 237
10.4 Lymfoproliferativní onemocnění spojená s léčbou metotrexatem ...................................... 237
11 Malignity z histiocytů a dendritických buněk
11.1 Histiocytární sarkom .........................................
11.2 Histiocytóza z Langerhansových buně
11.3 Sarkomy/nádory z dendritických buněk ...........
11.4 Akutní leukemie z dendritických buněk
12 Mastocytózy ........................................................
12.1 Systémová mastocytóza
12.2 Mastocytární leukemie
13 Metastatické postižení kostní dřeně .................
Apendix I Metodické poznámky ...............................................
Apendix II
Přehled WHO klasifikace nádorů hematopoetické a lymfatické tkáně ........................
Přehled použitých zkratek
ABalciánová modř (alcian blue)
ABLakutní bazofilní leukemie
aCMLatypická chronická myeloidní leukemie
AcPkyselá fosfatáza (acid phosphatase)
AELakutní eozinofilní leukemie
AILTangioimunoblastický T-lymfom (angioimmunoblastic T-cell lymphoma)
ALCLanaplastický velkobuněčný lymfom (anaplastic large cell lymphoma)
ALIPabnormální lokalizace nezralých prekurzorů (abnormal localization of immature precursors)
ALLakutní lymfoblastická leukemie
AMLakutní myeloidní leukemie
AML-MLDakutní myeloidní leukemie s multilineární dysplazií
ANAE α-naftyl-acetát-esteráza
ANBE α-naftyl-butyrát-esteráza
APakcelerovaná fáze (accelerated phase)
APLakutní promyelocytární leukemie
APMFakutní panmyelóza s myelofibrózou
ATLLleukemie/lymfom z T-buněk dospělých (adult T-cell leukaemia/lymphoma)
ATRA all-trans-retinová kyselina (all-trans-retinoic acid)
BPblastická fáze (blast phase)
CAEnaftol-AS-D-chloroacetát-esteráza
CALLAcommon acute lymphoblastic leukaemia antigen
CDcluster of differentiation
CELchronická eozinofilní leukemie
cHLklasický Hodgkinův lymfom (classical Hodgkin lymphoma)
CIMFchronická idiopatická myelofibróza
CLLchronická lymfatická leukemie
CLL/PLchronická lymfatická leukemie/prolymfocytární leukemie
CMLchronická myeloidní leukemie
CMMLchronická myelomonocytární leukemie
CMPDchronická myeloproliferativní onemocnění (chronic myeloproliferative diseases)
CNLchronická neutrofilní leukemie
CNScentrální nervový systém
CPchronická fáze (chronic phase)
cycytoplazmatický
DLBCLdifuzní velkobuněčný B-lymfom (diffuse large B-cell lymphoma)
DNAkyselina deoxyribonukleová (deoxyribonucleic acid)
DSDownův syndrom
EBVvirus Epsteina-Barrové
ECPEvropská klinická a patologická (kritéria) (European Clinical and Pathological)
EDTAetylen-diamino-tetraacetát
EGILEvropská skupina pro imunologickou klasifikaci leukemií (European Group for the Immunological Classification of Leukemias)
EMAepitelový membránový antigen
EMS8(eight)p11 myeloproliferativní syndrom
EORTCEvropská organizace pro výzkum a léčení nádorů (European Organization for Research and Treatment of Cancer)
ETesenciální trombocytemie
FABfrancouzsko-americko-britská (klasifikace)
FCMprůtoková cytometrie (flow cytometry)
FISHfluorescenční in situ hybridizace
FLfolikulární lymfom
FSCforward scatter
G-E, G/Egranulocyto-erytroidní
GPAglykoforin A (glykophorin A)
HCDnemoc těžkých řetězců (heavy chain disease)
HCLleukemie z vlasatých buněk (hairy cell leukaemia)
HEShypereozinofilní syndrom
HIVvirus lidského imunodeficitu (human immunodeficiency virus)
HLHodgkinův lymfom
HLAlidský leukocytární antigen (human leukocyte antigen)
H-RSbuňka Hodgkinova/Reedové-Sternbergova
HTLV-1virus lidské T-leukemie 1 (human T-cell leukaemia virus 1)
Igimunoglobulin
IgHtěžký řetězec imunoglobulinů (heavy chain immunoglobulin)
IgLlehký řetězec imunoglobulinů (light chain immunoglobulin)
IPSSMezinárodní prognostický skórovací systém (International Prognostic Scoring System)
ITDinterní tandemová duplikace
JMMLjuvenilní myelomonocytární leukemie
KDkostní dřeň
L&Hlymfoidně histiocytární (buňka)
LBLlymfoblastický lymfom
LGLvelký granulární lymfocyt (large granular lymphocyte)
LGLLleukemie z velkých granulárních lymfocytů
LCHhistiocytóza z Langerhansových buněk (Langerhans cell histiocytosis)
LPLlymfoplazmocytární lymfom
LYGlymfomatoidní granulomatóza
MALTslizniční lymfatická tkáň (mucosa-associated lymphoid tissue)
MCLlymfom z buněk pláště (mantle cell lymphoma)
MDSmyelodysplastický syndrom
MDS/MPDmyelodysplasticko-myeloproliferativní onemocnění (myelodysplastic/myeloproliferative diseases)
MDS-fmyelodysplastický syndrom s fibrotizací
MFmyelofibróza
M-FISHmnohobarevná fluorescenční in situ hybridizace
MGGMay-Grünwald a Giemsa (barvení)
MGUSmonoklonální gamapatie nejasného významu (monoclonal gammopathy of undetermined significance)
MICmorfologická-imunologická-cytogenetická (klasifikace)
MIC-Mmorfologická-imunologická-cytogenetická a molekulárně genetická (klasifikace)
MLmaligní lymfom
MLBCLmediastinální velkobuněčný B-lymfom (mediastinal large B-cell lymphoma)
MPOmyeloperoxidáza
MyFmycosis fungoides
MZLlymfom z B-buněk marginální zóny (marginal zone B-cell lymphoma)
N/Cnukleo-cytoplazmatický
NAPneutrofilní alkalická fosfatáza
NCjaderná buňka (nucleated cell)
NECnon-erytroidní buňka (non-erythroid cell)
NKpřirozený zabíječ (natural killer)
NLPHLnodulární Hodgkinův lymfom s predominancí lymfocytů (nodular lymphocyte predominant Hodgkin lymphoma)
NMZLnodální lymfom z B-buněk marginální zóny (nodal marginal zone B-cell lymphoma)
NSEnespecifická esteráza
PASkyselina jodistá a Schiffovo reagens (periodic acid Schiff’s reagens)
PCLplazmocytární leukemie
PCRpolymerázová řetězová reakce (polymerase chain reaction)
PDWšíře distribuční křivky objemu trombocytů (platelet distribution width)
PELprimární exsudativní lymfom (primary effusion lymphoma)
PhPhiladelphia chromozom
PKperiferní krev
PLLprolymfocytární leukemie
PNHparoxyzmální noční hemoglobinurie
PSAprostatický specifický antigen
PTCLperiferní T-lymfom (peripheral T-cell lymphoma)
PTLDpotransplantační lymfoproliferativní onemocnění (post-transplant lymphoproliferative disorders)
PVpolycythaemia vera
PVSGstudijní skupina pro polycythaemia vera (Polycythaemia Vera Study Group)
RArefrakterní anemie
RAEBrefrakterní anemie s excesem blastů
RAEB-Trefrakterní anemie s excesem blastů v transformaci
RARSrefrakterní anemie s prstenčitými sideroblasty (refractory anaemia with ringed sideroblasts)
RCMcelková erytrocytární masa (red cell mass)
RCMDrefrakterní cytopenie s multilineární dysplazií
RCMD-RSrefrakterní cytopenie s multilineární dysplazií a s prstenčitými sideroblasty (refractory cytopenia with multilineage dysplasia and ringed sideroblasts)
RDWšíře distribuční křivky objemu erytrocytů (red cell distribution width)
REALRevidovaná evropsko-americká klasifikace lymfomů (Revised European-American Lymphoma (Classification))
RSReedové-Sternbergova (buňka)
RTGrentgen
RT-PCRreverzně transkriptázová polymerázová řetězová reakce spovrchový (surface)
SBBSudanová čerň B (Sudan black B)
SLLlymfom z malých lymfocytů (small lymphocytic lymphoma)
SLVLsplenický lymfom s vilózními lymfocyty
SMsystémová mastocytóza
SM-AHNMDsystémová mastocytóza asociovaná s klonálním hematologickým onemocněním jiné než mastocytární linie (systemic mastocytosis with associated clonal, haematological non-mast cell lineage disease)
SMZLsplenický lymfom z B-buněk marginální zóny (splenic marginal zone lymphoma)
SSSézaryho syndrom
SSCside scatter
TCRT-buněčný receptor (T-cell receptor)
THRBCLvelkobuněčný B-lymfom bohatý na T-lymfocyty/histiocyty (T-cell/histiocyte rich large B-cell lymphoma)
TdTterminální deoxynukleotidyl-transferáza
TMDtranzientní myeloproliferativní onemocnění (transient myeloproliferative disease)
TRAPtartarát-rezistentní kyselá fosfatáza (tartrate-resistant acid phosphatase)
Uneklasifikovatelný (unclassifiable)
vHCLvariantní leukemie z vlasatých buněk (variant hairy cell leukaemia)
WBCwhite blood cell (leukocyt)
WHOSvětová zdravotnická organizace (World Health Organization)
WMWaldenströmova makroglobulinemie
Předmluvy recenzentů
Hematoonkologický atlas pražských autorů MUDr. Petry Kačírkové a MUDr. Víta Campra je na domácí poměry ojedinělým dílem, a to jak svým zaměřením, tak také rozsahem.
V minulosti byl hematologický atlas u nás sestaven vlastně jen Vilémem Hulem v 50. letech minulého století. Jednalo se o publikaci, která poskytovala obecné principy a základní informace cytomorfologické diagnostiky a představovala úvod do hematologické morfologie v celém rozsahu potřeby tehdejší doby.
Předkládaná publikace se zaměřuje na hematoonkologickou morfologickou diagnostiku a v tomto směru poskytuje detailní a zároveň komplexní zpracování, a to jak v obrazové, tak i v popisné části. Vychází z dokonalých znalostí problému a odborné literatury, ale i z vlastních bohatých zkušeností a schopnosti jejich využití. Dílo má pozoruhodný obsah v obrazové i popisné části. Zpracovává problematiku cytologickou, histologickou, imunocytologickou, cytogenetickou a molekulárně biologickou. Klasifikace chorob jsou převzaty z posledních literárních odkazů, zároveň však sledují i jejich vývoj a změny. Atlas zahrnuje všechny choroby zařazované v současnosti do kapitoly hematologické onkologie.
Publikace je po úvodní části a seznamu zkratek rozdělena do následujících kapitol: 1. Chronická myeloproliferativní onemocnění, 2. Myelodysplasticko-myeloproliferativní onemocnění, 3. Myelodysplastický syndrom, 4. Akutní myeloidní leukemie, 5. Obtížně klasifikovatelné akutní leukemie, 6. Malignity z prekurzorových B- a T-buněk, 7. Malignity ze zralých B-buněk, 8. Malignity ze zralých T- a NK-buněk, 9. Hodgkinův lymfom, 10. Lymfoproliferativní onemocnění spojená s imunodeficity, 11. Malignity z histiocytů a dendritických buněk, 12. Mastocytózy, 13. Metastatické postižení dřeně. V apendixech jsou v části I Metodické poznámky a v části II WHO klasifikace
nádorů hematopoetické a lymfoidní tkáně. Na závěr je zpracován podrobný rejstřík. Uspořádání je velmi přehledné, logicky navazující a vyčerpávající.
Obrazová část je značně obsažná a popisuje tak řka všechny zobrazené buňky, což není úplně běžné. Celé dílo obsahuje téměř 600 obrázků a je doloženo více než 150 literárními odkazy. V naprosté většině využívá vlastního materiálu, pouze z menší části materiálu zapůjčeného spolupracujícími pracovišti.
Nebráním se tomu opakovaně zdůraznit, že se jedná o dílo svým zaměřením, obsahem i rozpětím zcela výjimečné, které poskytuje velmi fundovaně, přitažlivě a přehledně detailní informace o laboratorní diagnostice hematoonkologických chorob. Obrazová část je sestavena velmi uvážlivě a je provázena instruktivním popisem a komentářem k buňkám, případně i dalším podrobnostem. Zároveň je třeba velmi vyzvednout kvalitu digitálního zpracování obrazové dokumentace.
Dílo je sestaveno nesmírně pečlivě a odráží obrovský kus práce. Pravděpodobně dnes nikde neexistuje dílo podobného charakteru, a proto by asi nebylo neskromné přeložit ho do angličtiny a publikovat rovněž v zahraničí. Je velmi pravděpodobné, že publikace vyvolá velký ohlas a vydobude si i odpovídající ocenění. Bez předbíhání událostem lze však říci už nyní, že předkládaný atlas je mimořádným příspěvkem k obohacení naší odborné literatury. Atlas bude nepochybně sloužit velmi širokému okruhu odborníků –hematologům, onkologům, cytologům, histologům, patologům, ale i studentům a teoretickým a výzkumným pracovníkům. Velmi si vážím toho, že jsem mohl být jedním z prvních, kterým se toto skvělé dílo dostalo do rukou.
V Brně 8. září 2007
Prof. MUDr. Miroslav Penka, CSc.
Dávno sa minuli doby, kedy sa medicínska diagnostika a liečba opierala o individuálne výkony jednotlivcov, hoci medzi nimi boli neraz vskutku výnimočné osobnosti. Dávno sa minuli doby medicínskych polyhistorov, ktorí boli považovaní za všeznalcov. Rovnako sa v postupne v miznúcej minulosti stráca pozícia patológa ako v zásade „neomylného“ diagnostika. Rozvoj modernej medicíny a medicínskych vied priniesol nielen explóziu poznatkov a pochopenie javov na subcelulárnej, génovej až molekulovej úrovni, ale súčasne aj prudký rozvoj nových a donedávna netušených technologických možností, ktoré umožňujú aplikácie nových diagnostických postupov. Je preto viac než logické, že dnešná medicína je tímovou prácou, založenou na multidisciplinárnej spolupráci a vzájomnej výmene a korelácii jednotlivých parametrov. Pritom platí, že v dobrom tíme sa nijako nestráca ani výnimočná individualita, naopak môže tu nájsť ešte lepšie uplatnenie. Multidisciplinárna spolupráca sa opiera nielen o spoluprácu kvalitných odborníkov jednotlivých medicínskych disciplín, ale rovnako aj o prelínanie viacerých diagnostických metód – od morfologických a funkčných cez imunologické až po genetické a molekulovo-biologické.
Dnešná moderná hematológia, hematoonkológia a hematopatológia sú snáď najlepším či najnázornejším príkladom pokroku doby, lebo práve výskum a štúdium „ľahko dostupných“ krvných a lymfatických buniek neraz umožnili revolučné zmeny nášho chápania choroby, jej príčiny, diagnos-
tiky a liečby. Veď už len samotná klasifikácia nádorových ochorení krvi, krvotvorných orgánov a lymfatického tkaniva podľa Svetovej zdravotníckej organizácie je tým najlepším príkladom multiparametrického klasifikačného a diagnostického prístupu, ktorý nachádza uplatnenie aj vo fáze voľby vhodnej liečby a monitorovania priebehu ochorenia.
Predložený atlas spĺňa požiadavky doby vhodnou voľbou autorského kolektívu, ktorý sa opiera o dlhoročné skúsenosti zainteresovaných špičkových pracovísk a pracovníkov v tejto oblasti. Rovnako viac než spĺňa požiadavky doby aplikáciou klasických morfologických, moderných imunodiagnostických, molekulovo-biologických a ďalších laboratórnych metód na súčasnej úrovni poznania hematológie a hematoonkológie. Je výsledkom dobrej a o recentné vedecké a odborné poznatky sa opierajúcej spolupráce klinika-hematológa a patológa. Táto monografia predkladá návody, návrhy a riešenia, ako postupovať v hematologickej a hematoonkologickej diagnostike, a bude tak určovať normy jak v hematologickej klinickej diagnostike a praxi, ako aj modernej bioptickej diagnostike, vrátane požiadaviek na aplikáciu poznatkov genetiky a molekulovej biológie do dennej praxe v prospech pacienta a liečiteľnosti jeho ochorenia.
V Martine 6. septembra 2007
Prof. MUDr. Lukáš Plank, CSc.
Hematologické atlasy vyšly u nás naposledy v 50. letech minulého století (Ławkowicz, W., Krzemińská-Ławkowiczová, I.: Hematologický atlas, Státní zdravotnické nakladatelství, 1953 a Hule, V.: Hematologický atlas, Slovenská akademie věd, 1955). Obsahovaly pouze základní informace a byly úvodem do hematologické cytologie v kontextu potřeby tehdejší doby. Zájemcům o hematologickou morfologii se kromě několika kvalitních zahraničních atlasů nabízí už jen základní obrazová dokumentace v učebnicích hematologie. Po delším rozvažování jsme se proto rozhodli vytvořit atlas věnující se morfologii alespoň hematologických malignit jakožto nejzávažnější skupině hematologických onemocnění.
Vodítkem při jeho tvorbě nám byla v současnosti platná klasifikace nádorů hematopoetické a lymfatické tkáně podle Světové zdravotnické organizace (World Health Organization – WHO), která byla publikována v roce 2001. Tato klasifikace standardizovala nomenklaturu a definovala jednotlivé typy hematologických malignit na základě integrace morfologických rysů s výsledky specializovaných vyšetření od imunofenotypizace přes cytogenetiku až po vyšetření molekulární. Tento trend nastolily již předchozí běžně užívané klasifikace (např. tzv. MIC klasifikace leukemií nebo REAL klasifikace lymfomů). Převratnost klasifikace WHO proti předchozím spočívá v tom, že poprvé zahrnuje všechny hematologické malignity. Přes komplexní přístup však diagnostika hematologických onemocnění stále vychází z morfologického obrazu a výsledky speciálních vyšetření se doplňují postupně v delším časovém horizontu. Cytologické vyšetření krve a kostní dřeně, případně histologické vyšetření kostní dřeně jsou u hematologických malignit většinou „prvním kontaktem“ s postiženou tkání. Na základě těchto vyšetření lze někdy udělat pravděpodobnou diagnózu, jindy nasměrovat pacienta ke specializovaným vyšetřením, která je nutno pro jejich často vysokou cenu indikovat velmi uvážlivě Dobře to lze ilustrovat na příkladu akutní myeloidní leukemie. Cytologický obraz je popsán prakticky v intencích klasické FAB klasifikace, poprvé publikované již v roce 1976 a s jistými modifikacemi přejaté do současného schématu. Doplňuje se vyšetřením imunofenotypu průtokovou cytometrií. Je-li potřeba, indikuje se trepanobiopsie kostní dřeně včetně imunohistologie. V další etapě pak dobíhají časově i finančně náročnější vyšetření cytogenetické a molekulárně genetické, na základě jejichž výsledků se pak jednotka definitivně zařadí do schématu WHO klasifikace.
Celý víceúrovňový diagnostický proces tak může trvat řadu dnů až několik týdnů, většinou je však nutné začít s terapií ještě před jeho definitivním ukončením. Tím v mnoha případech vzrůstá význam klasického morfologického přístupu jakožto „první linie“ v rozpoznání správné diagnózy. A právě pro morfology je určen náš atlas. Žádná klasifikace není definitivní a s postupujícím časem a pokračujícím poznáním etiologie a patogeneze jednotlivých onemocnění především na molekulární úrovni se vyvíjí a modifikuje. My jsme se rozhodli pro přehlednost a lepší orientaci dodržet schéma dosud platné klasifikace WHO a podrobněji ilustrovat jednotlivé nozologické jednotky. Rozhodli jsme se takto přesto, že od její první publikace logicky vznikla celá řada polemik a návrhů na její modifikaci – např. ve skupině chronických myeloproliferativních onemocnění, myelodysplastického syndromu, malignit ze zralých T- a NK-buněk atd. Nicméně jsme se snažili tyto změny a návrhy zachytit a v textu je uvádíme. Volně přiřazujeme kapitolu poslední, zabývající se metastatickým postižením kostní dřeně, neboť se domníváme, že hraje velmi důležitou a neoddělitelnou roli v diferenciální diagnostice primárně dřeňových maligních procesů Ve stručném úvodním textu uvádíme u každé skupiny onemocnění definici a základní morfologické rysy, některé údaje jsou pro větší přehlednost ve formě tabulek. Pro doplnění a lepší pochopení jsme přiřadili údaje o imunofenotypizačním vyšetření a stručné poznámky o cytogenetickém a molekulárně genetickém vyšetření, aniž bychom je ilustrovali – zde odkazujeme na specializované publikace. Z důvodů prostorových jsou velmi limitované a neúplné poznámky diferenciálně diagnostické, rovněž se nevěnujeme obrazu normální periferní krve a kostní dřeně, které by měly být poučeným čtenářům dobře známé. Rozsah publikace bohužel neumožnil ani podrobnější pojednání vyšetření kostní dřeně po léčbě, včetně potransplantačních kontrolních analýz a diagnostiky iniciálních relapsů chorob. Na základní literaturu musíme odkázat i v případě základní metodiky zpracování a barvení odebraného materiálu.
Těžiště našeho atlasu určeného pro morfology logicky leží v části obrazové. Maximum informací je obvykle získáno z cytologického vyšetření periferní krve a aspirátu kostní dřeně, doplněného histologickým vyšetřením trepanobiopsie kostní dřeně, které je diagnosticky rozhodující pouze v některých případech (např. chronické myeloproliferace či lymfomy). Tomu zhruba odpovídá i poměr zastoupení cytologických a histologických obrázků v naší publikaci celkově i v rámci jednotlivých kapitol. Důležitost
histologického vyšetření však vzrůstá a ještě více bude zdůrazněna v připravované revizi klasifikace WHO. Popisy k jednotlivým fotografiím jsme se snažili udělat podrobné, tak aby se v nich čtenář snadno orientoval.
V cytologii převládají fotografie preparátů v základním, tzv. panoptickém barvení (podle Maye-Grünwalda a Giemsy), doplňující jsou cytochemické metody jako průkaz myeloperoxidázy, nespecifických esteráz, PAS-reakce, průkaz trojmocného železa a další. V histologické části atlasu rovněž převládá základní barvení hematoxylinem a eozinem, méně často je doplněno barvení podle Giemsy, stříbření retikulinových vláken, histochemický průkaz chloroacetát-esterázy či barvení berlínskou modří. Zejména v kapitolách o lymfoproliferacích jsou použity výsledky imunohistologického průkazu základních lymfoidních znaků
Původní zvětšení cytologických obrázků je 1000×, méně často 200× či 600×. Zvětšení však v popisech neuvádíme, neboť při zpracování fotografií jsme přistoupili ke zhotovení různě velkých výřezů a čtenář se může relativně snadno orientovat podle velikosti obligátně přítomných erytrocytů (jejichž průměr je 7–8 μm). V případě složených cytologických obrázků je jejich výsledné zvětšení identické. Původní zvětšení histologických fotografií je obvykle 400× a někdy 1000×, méně často je použito zvětšení menší až přehledné 200× a ojediněle 100× či 40×. Ani v těchto případech zvětšení neuvádíme.
Teprve v průběhu psaní atlasu a hlavně při dokumentování jednotlivých jednotek jsme si uvědomili, do jak velkého a náročného úkolu jsme se pustili. Většina případů pochází ze sestavy pacientů léčených a obvykle i diagnostikovaných v Ústavu hematologie a krevní transfuze (ÚHKT) v Praze, bioptické vyšetření bylo prováděno v Ústavu patologie a molekulární medicíny 2. LF UK a FN v Motole. Děkujeme vedení těchto institucí za podporu, ošetřujícím lékařům a všem pracovníkům, kteří se podíleli na přípravě preparátů a bez jejichž hluboké erudice a zručnosti by jistě nemohla vzniknout ani jedna fotografie tohoto atlasu. Náš dík patří také všem pacientům, fotografie jejichž nálezů v krvi a kostní dřeni jsme pro publikaci použili. Jsme též vděčni sponzorům, díky jejichž pomoci mohlo být toto vysoce výrobně nákladné dílo vydáno.
Vzhledem k tomu, že jsme na našich pracovištích neměli příležitost některé nozologické jednotky diagnostikovat – buď proto, že jsou příliš vzácné, nebo proto, že například nejsme zaměřeni na hematologii dětského v ě ku – obrátili jsme se i na další pracovišt ě v Č eské republice a v zahraničí. Náš velký dík za zapůjčení případů patří prim. MUDr. J. Blatnému, Ph.D., z Oddělení klinické hematologie FN Brno, doc. MUDr. T. Kozá-
kovi, Ph.D., z Hemato logické kliniky FN Královské Vinohrady v Praze a vrchní laborantce tohoto pracoviště paní H. Šubrtové, prim. MUDr. I. Hochové z Oddělení klinické hematologie FN Motol a prof. MUDr. J. Starému, DrSc., z Kliniky dětské hematologie 2. LF UK Praha, doc. MUDr. B. Friedmannovi, CSc., in memoriam z 1. interní kliniky 1. LF UK Praha a MUDr. P. Žákovi, Ph.D., z Hematologické kliniky FN Hradec Králové. Za poskytnutí fotografií děkujeme dr. Bridget S. Wilkins z Clinical & Laboratory Sciences, University of Newcastle Upon Tyne, Velká Británie, a prof. MUDr. J. Hastkovi z III. Medizinische Universitätsklinik, Fakultät für Klinische Medizin Mannheim, Universität Heidelberg, SRN. Poděkování patří také prof. ing. K. Michalové, DrSc., a RNDr. J. Březinové, Ph.D., z ÚHKT a Oddělení cytogenetiky VFN Praha za cenné připomínky k cytogenetickým poznámkám v textu. Děkujeme také MUDr. J. Schwarzovi, CSc., z ÚHKT Praha, RNDr. M. Kalinové z Ústavu patologie a molekulární medicíny 2. LF UK a FN v Motole a doc. MUDr. J. Trkovi, CSc., z Laboratoře molekulární genetiky 2. LF UK Praha za připomínky k molekulárně genetickým poznámkám. Poděkování patří rovněž prof. MUDr. K. Smetanovi, DrSc., z ÚHKT Praha za podporu a cenné rady v oblasti cytologie. Za neocenitelné rady a připomínky k celému textu vděčíme MUDr. Kateřině Benešové, CSc., z ÚHKT Praha.
Děkujeme také recenzentům za jejich mimořádně pečlivou práci a podnětné poznámky, které přispěly ke zvýšení úrovně celého díla. Veškeré případné nepřesnosti a omyly v textu ale padají samozřejmě na hlavu autorů. Za výslednou podobu atlasu vděčíme pracovníkům nakladatelství Grada Publishing, bez jejichž nadstandardního přístupu nelze obdobné na grafiku náročné dílo vydat. Zvláštní dík patří panu A. Plickovi za jeho výjimečně zodpovědný, precizní a velkými zkušenostmi podložený přístup při společném zpracování fotografického materiálu.
Doufáme, že všem, kteří si náš atlas prolistují, přinese tato kniha snadný a přehledný přístup k základním informacím o morfologické diagnostice hematologických malignit a že se nám podaří na čtenáře přenést alespoň část naší poněkud zvrácené vášně pro mikroskopickou diagnostiku poměrně uzavřené skupiny závažných onemocnění. A pokud si někdo položí tuto knihu na dosah od mikroskopu a v případě pochybností v ní bude listovat, naše nejtajnější sny budou naplněny.
Praha, květen 2007
Petra Kačírková a Vít Campr
1 Chronická myeloproliferativní onemocnění
Chronická myeloproliferativní onemocnění (chronic myeloproliferative diseases – CMPD) jsou klonální hematopoetická onemocnění kmenové buňky charakterizovaná proliferací jedné či více myeloidních linií (granulocytární, erytroidní či megakaryocytární) v kostní dřeni (KD). Proliferace je efektivní, spojená se zvýšenými počty granulocytů, erytrocytů či trombocytů v periferní krvi (PK) a vyzrávání je relativně normální. Častá je splenomegalie a hepatomegalie, způsobená sekvestrací nadbytečných krevních buněk, extramedulární hematopoezou, leukemickou infiltrací či kombinací těchto faktorů. Ačkoliv jde o onemocnění chronická a v začátku nenápadná, mají různě silnou tendenci podléhat klonální evoluci a buď progredovat v selhání kostní dřeně spojené s myelofibrózou či inefektivní hematopoezou, nebo většina z nich transformovat do akutní leukemie, označované jako blastická fáze (transformace, zvrat), resp. sekundární akutní myeloidní leukemie. Cytogenetické či molekulární známky klonální evoluce tak ukazují na akceleraci onemocnění a hrozící blastickou transformaci.
Nejdůležitější změny oproti dřívějším diagnostickým přístupům přináší klasifikace WHO (2001) zejména ve skupině některých Ph negativních CMPD. Nedávno byla kritéria WHO modifikována v návrhu Evropských klinických a patologických (ECP) kritérií (2002) (viz tab. 1.4, 1.5, 1.8).
WHO, event. ECP kritéria jsou užívána převážně ve střední Evropě, nejsou dosud široce uznávána, ale umožňují citlivější záchyt časných stadií onemocnění a rozlišení esenciální trombocytemie (ET), polycythaemia vera (PV) a prefibrotického stadia chronické idiopatické myelofibrózy (CIMF). Přestože tato ECP kritérii definovaná časná stadia nesplňují původní diagnostická kritéria PVSG (Polycythaemia Vera Study Group) ani WHO, mohou být klinicky provázena závažnými komplikacemi, kterým je možné při včasné diagnóze předejít. Diferenciální diagnostika mezi těmito jednotkami je možná pouze histologicky, proto jsou histologická kritéria nedílnou součástí diagnostiky. Pouze v trepanobiopsii kostní dřeně je možno spolehlivě hodnotit přítomnost a stupeň fibrotizace (viz tab. 1.6) a popsat četnost, distribuci a morfologii megakaryocytů jako důležitého diferenciálně diagnostického znaku u Ph negativních CMPD. Je nezbytné indikovat trepanobiopsii KD ještě před zahájením léčby, neboť jakákoli terapeutická intervence může morfologický obraz natolik modifikovat, že se vyšetření může stát nepřínosným a onemocnění se nezdaří přesně klasifikovat. Je nutné zdůraznit, že histolo-
gicky lze ve všech případech odlišit CMPD od reaktivních (sekundárních) erytrocytóz, leukocytóz a trombocytóz. Po stránce genetické jsou CMPD charakterizována chromozomálními změnami postihujícími geny kódující různé tyrozinkinázy. Chronická myeloidní leukemie (CML) je definována přítomností fúzního genu BCR-ABL s tyrozinkinázovou aktivitou, u významné části chronických eozinofilních leukemií (CEL) je detekován fúzní gen FIP1L1-PDGFRα, také s tyrozinkinázovou aktivitou. Zásadním mezníkem se stal nedávný objev bodové mutace V617F genu JAK2 (Janus kinase), lokalizovaného na chromozomu 9p24 u CMPD typu PV, CIMF a ET. Mutace vede k aktivaci tohoto tyrozinkinázového genu s následnou proliferační autonomií postižených buněk a je příčinou trilineární myeloproliferace s rozmanitou klinickou manifestací. CMPD a myelodysplasticko-myeloproliferativní onemocnění (viz kap. 2) bez této mutace reprezentují skupinu příbuznou, ale s odlišnou molekulární etiologií. Zcela nedávno byly zjištěny i alternativní typy mutací genu JAK2. Přítomnost mutace JAK2 tak pravděpodobně zásadně ovlivní diagnostiku, klasifikaci i léčebný přístup k těmto onemocněním.
1.1 Chronická myeloidní leukemie
(obr. 1.1–1.38)
Chronická myeloidní leukemie (CML) je myeloproliferativní onemocnění vycházející z pluripotentní kmenové buňky a je charakterizováno přítomností Philadelphia (Ph) chromozomu a/nebo BCR/ABL fúzního genu. Abnormální fúzní gen je přítomen nejen v buňkách myeloidní řady, ale také v buňkách lymfoidních. Onemocnění probíhá ve dvou až třech fázích – chronická fáze (chronic phase – CP) je následovaná akcelerovanou fází (accelerated phase – AP) a/nebo blastickou fází (blast phase – BP), resp. blastickým zvratem.
V chronické fázi je v PK leukocytóza, často velmi výrazná, se „stovkovými“ hodnotami, daná především výrazným zmnožením neutrofilů. Jsou přítomna všechna vývojová stadia (posun doleva), avšak nejvíce jsou zastoupeny segmenty a myelocyty. Častá bývá absolutní bazofilie, případně eozinofilie. Může být mírná absolutní monocytóza. Ve vzácných případech s přítomností p190bcr/abl proteinu (viz níže) bývá výrazná monocytóza absolutní i relativní. Počet trombocytů je normální nebo zvýšený, někdy i na hodnoty kolem 1000 × 109/l. Častá je mírná normochrom-
ní normocytární nebo makrocytární anemie. Ojediněle lze v nátěru nalézt erytroblasty či holá jádra megakaryocytů. Skóre alkalické fosfatázy v neutrofilech (NAP) je snížené až nulové.
Aspirát KD je hypercelulární, s vysokým granulocytoerytroidním (G-E) poměrem, většinou s extrémní proliferací neutrofilní granulopoezy, která vyzrává. Nejsou přítomny dysplastické změny a blasty vždy tvoří méně než 10 %, obvykle však méně než 5 % jaderných buněk (nucleated cells – NC). Zmnoženy bývají také elementy bazofilní a/nebo eozinofilní řady. Časté je zmnožení megakaryopoezy, megakaryocyty bývají poměrně malé, s hypolobulovanými jádry. Erytropoeza bývá zastoupena relativně sníženě. Někdy mohou být zastiženy střádací buňky typu „sea-blue“ makrofágů nebo pseudo-Gaucherových makrofágů, které střádají zbytky buněk a lipidové inkluze pocházející z buněčných membrán granulocytů. Jde o důsledek insuficience enzymatického systému degradujícího glukocerebrosidy při zvýšeném buněčném obratu.
Histologie KD: Přestože trepanobiopsie KD není v klasifikaci WHO vyžadována ani jako vedlejší diagnostické kritérium, histologické vyšetření před započetím léčby může přinést prognosticky významné informace. Histologický obraz CML je variabilní a umožňuje rozlišení do tří subtypů – granulocytární, bohatý na megakaryocyty a myelofibrotický (Thiele et al., 2000).
V granulocytárním subtypu je KD hypercelulární s převažující proliferací granulocytární řady. Maximum elementů granulocytární řady je lokalizováno peritrabekulárně, s vyzráváním směrem centrálně. Blasty nejsou výrazně zmnoženy. Četné jsou elementy eozinofilní granulopoezy. Poměr mezi granulocytární a erytroidní složkou se zvyšuje i přes hodnoty 10 : 1, ložiskově může červená řada zcela chybět.
V subtypu CML bohatém na megakaryocyty jsou megakaryocyty výrazně zmnoženy a někdy se shlukují. Často bývají menší než u ostatních CMPD, popisují se i tzv. trpasličí („dwarf“) megakaryocyty.
Vyčlenění myelofibrotického subtypu CML je problematické, neboť přítomnost fibrotizace jde obvykle ruku v ruce se zmnožením megakaryocytární linie, navíc oba předchozí subtypy mohou v průběhu onemocnění do myelofibrózy
přecházet. Nicméně je jisté, že případy s fibrózou v době diagnózy mají horší prognózu.
Nález st ř ádacích makrofágů , pseudo-Gaucherových buněk, je v trepanobiopsii častější než v aspirátu KD. Siderofágy nebývají přítomny, není to však známkou nedostatku zásobního železa, nýbrž jeho změněné distribuce.
FCM: V diagnostice chronické fáze CML nehraje imunofenotypizace významnou roli. Ve vzorcích PK i KD převažují elementy s fenotypem granulocytů (CD33+ CD13+ CD15+), blasty (CD34+ HLA-DR+ CD33+ CD38+) nejsou zmnoženy. Toto vyšetření nám nepomůže ani v odlišení CML-CP od leukemoidní reakce.
Genetika: Standardním cytogenetickým vyšetřením se u naprosté většiny případů nachází specifická chromozomální změna – Philadelphia chromozom, který je většinou výsledkem reciproké translokace mezi chromozomy 9 a 22, t(9;22)(q34;q11). Při této translokaci dochází ke spojení genů BCR a ABL za vzniku fúzního genu, který kóduje chimerický protein bcr/abl o hmotnosti 210 kD (p210bcr/abl).
Gen BCR se téměř u všech případů CML láme v oblasti nazývané „major“ (M-BCR). Ve velmi vzácných případech dochází ke zlomu genu BCR v oblasti nazývané „mikro“ (mikro-BCR) a spojením s genem ABL vzniká atypický protein o hmotnosti 230 kD (p230bcr/abl). Zcela výjimečně u CML může v genu BCR dojít ke zlomu v oblasti nazývané „minor“ (m-BCR) za vzniku fúzního genu a následně atypického proteinu o hmotnosti 190 kD (p190bcr/abl). Zlom v této oblasti je však typický spíše pro pacienty s Ph+ akutní lymfoblastickou leukemií. Fúzní gen BCR/ABL pomocí molekulárních metod, event. fluorescenční in situ hybridizace (FISH), nacházíme u všech diagnostikovaných CML, tedy včetně případů, kdy není Ph chromozom detekován cytogeneticky – v těchto případech mluvíme o tzv. kryptické translokaci t(9;22).
Akcelerovaná fáze je charakterizovaná přítomností jednoho či více kritérií uvedených v tabulce 1.1. Dysplazie granulopoezy, přítomnost extrémně zmnožených dysplastických megakaryocytů a/nebo retikulinová či kolagenní fibrotizace jsou také často známkou CML-AP.
Blastická fáze neboli blastický zvrat odpovídá akutní leukemii a je charakterizována přítomností jednoho či více kritérií uvedených v tabulce 1.2. Ve většině případů
Tab. 1.1 Kritéria WHO pro diagnózu akcelerované fáze CML
1. Blasty tvoří 10–19 % WBC v periferní krvi a/nebo 10–19 % NC v kostní dřeni
2. Bazofily v periferní krvi ≥ 20 %
3. Perzistující trombocytopenie < 100 × 109/ nezpůsobená terapií
4. Perzistující trombocytemie > 1000 × 109/l neodpovídající na terapii
5. Zvětšující se objem sleziny a stoupající počet WBC nereagující na terapii
6. Cytogenetický průkaz klonální evoluce
Diagnóza AP-CML vyžaduje splnění alespoň jednoho kritéria.
Tab. 1.2 Kritéria WHO pro diagnózu blastického zvratu CML
1. Blasty tvoří ≥ 20 % WBC v periferní krvi nebo ≥ 20 % NC v kostní dřeni
2. Prokázaná proliferace blastů v extramedulární lokalizaci
3. Velké agregáty nebo clustery blastů v biopsii kostní dřeně
Diagnóza BP-CML vyžaduje splnění alespoň jednoho kritéria.
(v 70 %) jde o blasty myeloidního původu v širším smyslu slova – nejčastěji myeloblasty (neutrofilní), méně často blasty eozinofilní, bazofilní, monocytární, megakaryocytární, vzácně erytroidní; může se jednat i o jejich kombinaci. V menší části případů (v 25 %) se jedná o lymfoblasty. Vzácně mohou být přítomny i dvě odlišné populace blastů – myeloidní a lymfoidní. Cytochemický nález je podobný jako u de novo akutních leukemií. V případě myeloblastů je možné prokázat myeloperoxidázu či pozitivitu SBB (Sudan black B – Sudanová čerň B), v případě monocytárního původu blastů pozitivitu nespecifických esteráz (α-naftyl-acetát-esterázy či α-naftyl-butyrát-esterázy). Hrubě granulární PAS pozitivita může být v případech proerytroblastového typu blastické krize či v případě
B-lymfoblastů. V případě T-lymfoblastů se může prokázat fokální pozitivita kyselé fosfatázy.
Histologie KD: V trepanobiopsii se v této fázi vzhled dřeně blíží akutní leukemii, výraznější však bývá příměs eozinofilů a bazofilů. K transformaci může dojít i extramedulárně či v kosti ve formě myelosarkomu.
FCM: Imunofenotypový nález v PK i KD v blastické fázi myeloidního původu v podstatě odpovídá různým typům AML vznikajících de novo. V leukemických buňkách je prokazatelná variabilní pozitivita myeloperoxidázy. Na jejich povrchu jsou detekovatelné znaky spojené s diferenciací do neutrofilní a monocytární řady (CD13, CD14, CD15, CD33, CD64, CD65, CD117 apod.), megakaryocytární řady (CD61, CD41) a/nebo erytroidní řady (glykoforin A). Myeloidní blasty (CD34+ HLA-DR+ CD33+ CD38+) často exprimují i jeden či více lymfoidních markerů, např CD7. V případě lymfoblastické BP je leukemická populace většinou tvořena prekurzorovými B-lymfoblasty s pozitivitou CD10, CD19, CD34, TdT nebo vzácněji prekurzorovými T-lymfoblasty s pozitivitou CD3, cyCD3, CD7, TdT apod. Podrobnější imunofenotyp odpovídá prekurzorovým B- či T-ALL/LBL. I v těchto případech se můžeme setkat s koexpresí jednoho či více myeloidních markerů
Genetika: V době akcelerace a blastického zvratu CML se objevují (či jim předcházejí) další cytogenetické změny, například +8, duplikace Ph chromozomu, i(17q), +19 apod. Nejčastější další molekulárně genetické změny se týkají genu MYC, může dojít k mutacím RAS genů, bodovým mutacím a amplifikaci BCR-ABL, delecím i mutacím TP53, RB1 apod.
Velmi vzácně (a téměř pouze u žen) se vyskytují případy BCR-ABL pozitivních myeloproliferací s izolovanou extrémní proliferací megakaryopoezy s trombocytemií, dříve někdy nazývané Ph+ esenciální trombocytemie (obr. 1.13–1.15), považované za formu časné manifestace chronické fáze CML. V PK nacházíme pouze trombocytemii (někdy extrémní – až kolem 4000 × 109/l), někdy s mírnou anemií a počet leukocytů může být zcela normální nebo jen lehce zvýšený, bez typického posunu doleva a bez bazofilie. Skóre NAP může být normální a často také nebývá přítomna splenomegalie. V aspirátu KD i v trepanobiopsii nacházíme zvýšenou proliferaci pouze megakaryopoezy, morfologie megakaryocytů je však zcela odlišná od esenciální trombocytemie, neboť na rozdíl od ní (viz kap. 1.6) jsou zde megakaryocyty poměrně malé a mají hypolobulovaná jádra. Někdy u těchto forem onemocnění postupně dojde k rozvoji typického obrazu CML s hyperplazií granulopoezy s typickým nálezem v PK. Zdá se, že tyto případy mají vyšší riziko rozvoje myelofibrózy a/nebo časného přechodu do blastické fáze. Z toho vyplývá nutnost vyšetření eventuální přítomnosti BCR-ABL fúzního
Chronická
genu u všech trombocytóz, u nichž není zřetelný sekundární původ. Totéž platí pro eozinofilie, u nichž byl sekundární původ vyloučen, neboť CML se může, byť velmi vzácně, manifestovat zmnožením pouze eozinofilní granulopoezy do obrazu HES/CEL.
1.2 Chronická neutrofilní leukemie
(obr. 1.39–1.44)
Chronická neutrofilní leukemie (CNL) je vzácné myeloproliferativní onemocnění charakterizované neutrofilií v PK a proliferací neutrofilní granulopoezy v KD, které se rovněž může blasticky transformovat. Dalšími obvyklými místy postižení jsou slezina a játra. Je nutno vyloučit reaktivní neutrofilii – infekce, zánětlivé procesy, tumory, zvláště Hodgkinův lymfom a malignity z plazmatických buněk. Při nápadnějších dysplastických rysech je nutno odlišit onemocnění ze skupiny MDS/MPD, zejména atypickou CML (aCML).
V PK je neutrofilie ≥ 25 × 109/l, převahu buněk tvoří segmentované formy. Nezralé formy granulocytů (promyelocyty, myelocyty a metamyelocyty) tvoří maximálně 10 %, blasty nejsou v PK přítomny téměř nikdy. Neutrofily mohou vypadat normálně, často však mají hrubá azurofilní granula, připomínající toxickou granulaci. Nejsou přítomny dysplastické změny granulocytů, stejně tak morfologie erytrocytů a trombocytů je normální. Může být mírná anemie a/nebo trombocytopenie. Je zvýšené skóre alkalické fosfatázy v neutrofilech.
Aspirát KD je většinou hypercelulární, se zvýšeným G-E poměrem i 20 : 1 a vyšším – hypercelularita je dána zvýšenou proliferací neutrofilní granulopoezy, avšak s normálním zastoupením blastů a promyelocytů. Nejsou přítomny signifikantní dysplastické změny v žádné z hematopoetických řad.
Histologie KD: Kostní dřeň je hypercelulární trilineární, obrazu dominuje granulocytární řada. Převažují vyzrávající neutrofily přiměřeného vzhledu, nedochází ke zmnožení blastů. Někdy může být přítomna i proliferace megakaryocytární a červené řady. Fibrotizace v chronické fázi nebývá zastižena buď vůbec, nebo je jen mírná.
FCM a genetika: Nejsou přítomny specifické imunofenotypické ani cytogenetické abnormality, ojediněle byla prokázána V617F mutace genu JAK2
1.3 Chronická eozinofilní leukemie a hypereozinofilní syndrom (obr. 1.45–1.53)
Chronická eozinofilní leukemie (CEL) je relativně heterogenní skupina chronických myeloproliferativních onemocnění charakterizovaných klonální proliferací eozinofilních prekurzorů, která má za následek zvýšené množství eozinofilů v krvi, kostní dřeni a periferních tkáních. Dochází k orgánovému poškození v důsledku leukemické infiltrace nebo jako následek uvolňování cytokinů, enzymů a jiných látek z eozinofilů. CEL je definována jako perzistující eozinofilie ≥ 1,5 × 109/l s prokázanou klonální chromozomální
aberací myeloidních buněk (event. je klonalita prokázána jiným způsobem) nebo se zvýšeným podílem blastů v krvi na 2–19 % WBC (white blood cells – leukocytů) či v kostní dřeni na 5–19 % NC.
Jako hypereozinofilní syndrom (HES) je definována perzistující eozinofilie ≥ 1,5 × 109/l (přičemž byl vyloučen její sekundární původ), při níž dochází k poškození orgánů a jejich dysfunkci. Není však prokázána klonalita eozinofilů a nejsou zmnoženy blasty.
Sekundárními, reaktivními příčinami eozinofilie, které je nutno vyloučit, jsou např. alergická a parazitární onemocnění, granulomatózní a zánětlivé procesy (vaskulitidy), hematologické malignity (zejména T-lymfomy, Hodgkinův lymfom, akutní lymfoblastová leukemie/lymfom, systémová mastocytóza). Je však nutno vyloučit také jiné hematologické malignity, u kterých jsou eozinofily součástí neoplastického klonu (CML, AML vč. AML s CBFβ/MYH11, jiná CMPD, MDS). V neposlední řadě je rovněž třeba vyloučit přítomnost nemaligní populace T-buněk s aberantním fenotypem v PK (CD3- CD4+ nebo CD3+ CD4- CD8-). Ty způsobují proliferaci eozinofilů produkcí interleukinu-5 a pro onemocnění s touto patogenezí se užívá název „lymfocytární varianta HES“ U části pacientů s odstupem dochází ke vzniku malignity z T-buněk.
V PK je eozinofilie u HES a CEL dána především zralými eozinofily, které mohou mít morfologické abnormality – poruchy granulace včetně hypogranularity, vakuoli-
zace cytoplazmy, hypo- či hypersegmentace jádra apod. Tyto změny však nejsou specifické, vyskytují se i u reaktivních eozinofilií. Častá je současná mírná neutrofilie, někdy monocytóza, event. bazofilie. U HES tvoří blasty maximálně 2 % WBC, u CEL mohou dosáhnout až 19 %. Aspirát KD je hypercelulární, což je dáno zmnožením eozinofilní granulopoezy. Někdy lze zastihnout Charcotovy-Leydenovy krystaly. Zvýšení počtu blastů na 5–19 % či dysplastické změny v jiných hematopoetických řadách svědčí pro neoplastický proces (nemusí se však nutně jednat o CEL). V eozinofilech lze prokázat kyanid-rezistentní peroxidázu. Eozinofily u CEL mohou být aberantně naftol-AS-D-chloroacetát-esteráza pozitivní.
Histologie KD: Kostní dřeň je trilineární hypercelulární s převládající pravidelně vyzrávající eozinofilní řadou. Různě vyjádřená fibróza je následkem působení různých látek uvolněných z eozinofilů při degranulaci. Také mohou být zastiženy Charcotovy-Leydenovy krystaly. Samotná histologie obvykle neumožňuje rozlišit CEL a HES.
FCM: Toto vyšetření není diagnosticky přínosné, protože eozinofily nemají specifický imunofenotyp. Kromě znaků typických pro granulocytární linii (CD15, CD33, CD65) eozinofily exprimují i znaky CD9, CD35, CD294, CD193, které se však nacházejí mimo jiné i na povrchu jiných leukocytů.
Genetika: U všech pacientů s HES a většiny pacientů s CEL je standardním cytogenetickým vyšetřením nalezen
Tab. 1.3 Kritéria pro diagnózu polycythaemia vera podle PVSG, modifikovaná kritéria PVSG a klasifikace WHO (zdroj: Michiels, JJ., Kvasnicka, HM., Thiele, J. Myeloproliferative disorders. Current perspectives on diagnostic criteria, histopathology and treatment in essential trombocythemia, polycythemia rubra vera and chronic idiopathic myelofibrosis. Verlag ME – Uwe Grunwald, 2005)
PVSGModifikovanáPVSGWHO
Hlavníkritéria
A1RCM
muž: > 36 ml/kg
žena: > 32 ml/kg
RCM > 25 % nad normální hodnotuRCM > 25 % nad normální hodnotu nebo
zvýšený Hb
muž: > 185 g/l
žena: > 165 g/l
A2arteriální pO2 > 92 %vyloučení sekundární polycytemievyloučení sekundární polycytemie
A3splenomegalie palpačněsplenomegalie palpačněsplenomegalie palpačně
A4 –cytogenetický průkaz klonality v buňkách kostní dřeně
průkaz klonality jiný než Ph chromozom nebo BCR/ABL fúzní gen
A5––spontánní EEC Vedlejšíkritéria
B1trombocyty > 400 × 109/ltrombocyty > 400 × 109/ltrombocyty > 400 × 109/l
B2leukocyty > 12 × 109/lleukocyty > 12 × 109/lleukocyty > 12 × 109/l
B3zvýšené skóre NAPsplenomegalie na ultrazvukubiopsie KD s obrazem typickým pro PV (panmyelóza s prominentní erytroidní a megakaryocytární proliferací)
B4–spontánní EEC nebo nízký sérový EPOnízký sérový EPO
Diagnóza
PV A1 + A2 + A3
A1 + A2 + dvě z B
A1 + A2 + A3 nebo A4
A1 + A2 + dvě z B
A1 + A2 + kterékoli z dalších A A1 + A2 + dvě z B
EEC – endogenní tvorba erytroidních kolonií (endogenous erythroid colony formation); EPO – erytropoetin; Hb – hemoglobin; RCM – celková erytrocytární masa (red cell mass)
normální karyotyp. U významné části pacientů s CEL lze molekulárně geneticky prokázat kryptickou del(4)(q12q12) dávající vznik fúznímu genu FIP1L1/PDGFRα s tyrozinkinázovou aktivitou. V některých případech CEL je možné nalézt např. +8, i(17q) a jiné. V případě translokace postihující 8p11 se jedná o tzv. 8p11 myeloproliferativní syndrom (EMS) – agresivní onemocnění, u kterého je eozinofilie spojená s T-lymfoblastovým lymfomem a rychle se transformuje do akutní leukemie, obvykle myeloidního typu.
1.4 Polycythaemia
vera (obr. 1.54–1.60)
Polycythaemia vera (PV) je myeloproliferativní onemocnění charakterizované zvýšenou produkcí erytrocytů, která je nezávislá na normální regulaci erytropoezy. Často je spojena se zvýšenou proliferací i ostatních myeloidních řad.
Existuje několik schémat diagnostických kritérií pro PV – původní a modifikovaná kritéria PVSG (tab. 1.3), kritéria WHO (tab. 1.3) a ECP kritéria (tab. 1.4).
Polycythaemia vera probíhá ve více stadiích – iniciálním, polycytemickém a terminálním.
Chronická myeloproliferativní
Iniciální (prepolycytemické) stadium, definované podle ECP kritérií, se obvykle projevuje jako mírná až značná klonální trombocytemie bez zvýšení hodnot červeného obrazu a může být mylně považováno za esenciální trombocytemii. K tomuto typu PV lze řadit i případy s mírně zvýšenými hodnotami červeného krevního obrazu, anebo se zvýšenými hodnotami RCM, které ještě nesplňují kritéria PVSG nebo WHO pro diagnózu PV.
Stadium proliferativní (polycytemické) je spojeno se zvýšením erytrocytární masy.
V PK je zvýšené množství normochromních normocytárních erytrocytů, v případě ztrátové sideropenie hypochromních mikrocytárních. Hemoglobin i hematokrit jsou výrazně zvýšeny. Častá je také současná neutrofilie a bazofilie. Ojediněle mohou být přítomny méně zralé granulocyty, nikoliv však blasty. Velmi častá je trombocytemie. Nátěr krve je nápadně silný. Často bývá zvýšené skóre alkalické fosfatázy v neutrofilech.
Aspirát KD bývá normo- či hypercelulární. Někdy bývá zvýšeně zastoupena erytropoeza, avšak často je G-E poměr normální a obraz kostní dřeně se blíží normálnímu nálezu v KD, nebýt často zmnožených megakaryocytů s velmi pestrou morfologií, od malých s hypolobulovaným
Tab. 1.4 Evropská klinická a patologická (ECP) kritéria pro diagnózu polycythaemia vera (zdroj: Michiels, JJ., Kvasnicka, HM., Thiele, J. Myeloproliferative disorders. Current perspectives on diagnostic criteria, histopathology and treatment in essential trombocythemia, polycythemia rubra vera and chronic idiopathic myelofibrosis. Verlag ME – Uwe Grunwald, 2005)
KlinickákritériaHistologickákritéria
grade1 RCM normální
A1B1 zvýšená buněčnost s trilineární myeloproliferací („panmyelóza“) proliferace a shlukování malých až velkých (pleomorfních) megakaryocytů absence železa bez výraznější zánětlivé reakce (plazmocytóza, buněčný detritus, eozinofily)
Hct muž: ≤ 0,51
žena: ≤ 0,48
Hb muž: ≤ 185 g/l
žena: ≤ 165 g/l
grade2 RCM zvýšena
muž: > 36 ml/kg
žena: > 32 ml/kg
Hct muž: > 0,51
žena: > 0,48
Hb muž: > 185 g/l
žena: > 165 g/l
A2 přetrvávající zvýšení počtu trombocytů (grade I: 400–1500, grade II: > 1500 × 109/l)
A3 splenomegalie palpačně, ultrazvukem nebo na CT (délka > 12 cm)
A4 granulocyty > 10 × 109/l a/nebo zvýšené skóre NAP při absenci horečky nebo infekce a/nebo overexprese PRV-1
A5 nízká plazmatická hladina EPO
A6 vyloučení SP
Diagnóza:
B2 spontánní tvorba erytroidních kolonií (EEC)
GradingmyelofibrózyuPV:
MF-0 prefibrotické stadium PV
MF-1 časné fibrotické stadium PV
MF-2 manifestní myelofibróza v PV
MF-3 pokročilá myelofibróza v PV (postpolycytemická myeloidní metaplazie)
B1 + kterékoli z A1 až A5 odpovídá PV. EEC potvrzuje PV a vylučuje SP.
A1 grade 1: iniciální latentní PV; A1 grade 2: rozvinutá polycytemická PV
EEC – endogenní tvorba erytroidních kolonií (endogenous erythroid colony formation); EPO – erytropoetin; Hb – hemoglobin; Hct – hematokrit; RCM – celková erytrocytární masa (red cell mass); SP – sekundární polycytemie (erytrocytóza)
Hematoonkologický atlas krve a kostní d řeně
jádrem až po obrovské formy s jádrem extrémně lobulovaným. V žádné z hematopoetických řad nejsou významné dysplastické změny, blasty nejsou zmnoženy. V případě deficitu železa může být erytropoeza mikronormoblastová a lze prokázat absenci zásobního železa a snížení či úplnou nepřítomnost sideroblastů. Případná blastická transformace PV může být předcházena myelodysplastickými změnami.
Histologie KD: Histologicky je již v prepolycytemickém stadiu a zejména v proliferativním stadiu dřeň hypercelulární, obvyklá je trilineární („panmyelóza“) ortotopní proliferace s nápadným zmnožením a zvětšením erytronů, které jsou bez podstatnějších dysplastických změn. Poměr granulocytární a erytroidní složky klesá pod 2 : 1. Zmnožené megakaryocyty se shlukují, střídají se formy hyperplastické se silně členěnými jádry i formy menší. Nález mírné dysplazie s nukleocytoplazmatickou asynchronií v megakaryocytární řadě (obraz zhruba mezi ET a CIMF) je tedy pro diagnózu PV přípustný, dysplazie však nebývá v ostatních hematopoetických řadách. Ani histologicky obvykle nelze prokázat železo. Nápadná je síť CD68 pozitivních makrofágů. S přechodem do postpolycytemické fáze se postupně vyvíjí retikulinová, později i kolagenní fibróza. Terminální stadium – „postpolycytemická myeloidní metaplazie“ či „spent“ fáze – je provázeno cytopeniemi (včetně anemie) způsobenými inefektivní hematopoezou, fibrózou KD, extramedulární hematopoezou a hypersplenismem. U významné části pacientů dochází k transformaci do akutní leukemie, častěji tehdy, byl-li v léčbě použit 32P či busulfan, resp. jiná cytostatika. Objem erytrocytární masy se normalizuje a postupně přechází v anemii, následkem myelofibrózy a myeloidní metaplazie dochází ke vzniku tzv. „leukoerytroblastického obrazu“ – vyplavování granulocytárních a erytroidních prekurzorů, s poikilocytózou a kapkovitými erytrocyty („tear drop“, dakryocyty).
Aspirát KD bývá vzhledem k fibróze hypocelulární, s příměsí periferní krve, někdy bývají zastiženy velmi polymorfní megakaryocyty. Může však jít také o tzv. „suchou“ punkci.
Histologie KD: V terminálním stadiu postpolycytemické myeloidní metaplazie, resp. ve „spent“ fázi, v KD dominuje fibróza retikulinová i kolagenní s poklesem buněčnosti, může být přítomna osteoskleróza. Stav je na podklad ě samotného histologického vyšet ř ení obtížn ě odlišitelný od pokročilé fáze CIMF. Je nezbytné pátrat po zmnožených a shlukujících se blastech, které předznačují možnou transformaci onemocnění.
FCM: Imunofenotypizačně nejsou u PV přítomny žádné specifické abnormality.
Genetika: Cytogenetické změny nacházíme v době diagnózy asi u 20 % pacientů, s progresí choroby jejich frekvence roste – nejčastěji jde o del(20)(q12), +8, +9, del(13q), parciální duplikaci 1q, změny (především ztráta heterozygocie) na 9p apod. Molekulárně geneticky je téměř u všech pacientů s PV detekována V617F mutace JAK2, na rozdíl od esenciální trombocytemie i v homozygotní formě (která signalizuje pokročilejší onemocnění ve srovnání s běžněji zjišťovanou mutací heterozygotní). Často prokazovaná zvýšená exprese PRV-1 a NF-E2 u těchto pacientů je pravděpodobně následkem této mutace a jejich detekce ztrácí na významu.
1.5 Chronická idiopatická myelofibróza
(obr. 1.61–1.81)
Chronická idiopatická myelofibróza (CIMF) je klonální myeloproliferativní onemocnění charakteristické především proliferací megakaryocytární a granulocytární řady v KD, spojené primárně s fibrotizací kostní dřeně a s extramedulární hematopoezou. Fibrotizace kostní dřeně je následkem sekundární stimulace fibroblastů KD růstovými faktory produkovanými klonální nádorovou populací.
Proces probíhá v několika stadiích. ECP diagnostická kritéria pro CIMF jsou uvedena v tabulce 1.5. Iniciální –prefibrotické stadium je charakterizované hypercelularitou KD bez výraznější fibrotizace. Fibrotické stadium se vyznačuje postupným narůstáním retikulinové a později kolagenní fibrotizace a často i osteomyelosklerózou (hodnocení stupně fibrotizace zachycuje tabulka 1.6) za současného ubývání hematopoezy a progrese extramedulární hematopoezy („myelofibróza s myeloidní metaplazií“) především ve slezině a játrech. U významné části pacientů (10–30 %) dochází k transformaci do sekundární AML.
V prefibrotickém stadiu u většinou asymptomatických pacientů dominuje nálezu v PK trombocytemie (až do 3000 × 109/l), často je přítomna jen lehce nadhraniční leukocytóza s absolutní neutrofilií, nikdy však nebývá anemie. Nález ojedinělých kapkovitých erytrocytů, erytroblastů či nezralých granulocytů je možný, avšak krajně vzácný a signalizuje spíše přechod v pokročilejší onemocnění. Mohou být nalezeny atypické trombocyty se značnou anizocytózou.
Aspirát KD bývá buněčný, nápadné je zmnožení megakaryocytů. Ty mají abnormální morfologii – jsou většinou abnormálně velké až gigantické, se značnou lobulizací jádra, někdy je naopak jádro obrovského megakaryocytu hypolobulované. Některé megakaryocyty mohou mít výrazné shlukování („clumping“) chromatinu. Častá je také přítomnost holých megakaryocytárních jader. Malé formy megakaryocytů jsou také přítomny, ale jsou mnohem méně časté než formy obrovské.
Histologie KD: Histologicky je kostní dřeň v tomto stadiu hypercelulární („panmyelóza“) s minimální retikulinovou fibrotizací centrovanou na cévní struktury nebo dokonce zcela bez fibrotizace (MF-0). Obrazu dominuje proliferace megakaryocytární a obvykle i granulocytární řady, erytropoeza je někdy redukovaná. Nápadné jsou kompaktní (až „kohezní“) shluky zmnožených megakaryocytů s maturačními defekty. Megakaryocyty nabývají různé velikosti (od obrovských až po mikromegakaryocyty), jejich jádra jsou často hyperchromní a jsou méně členěná, takže nabývají až „obláčkovitého“ („cloud-like“) vzhledu, zastihnou se i „nahá jádra“. Vzhled a distribuce megakaryocytů jsou základním diferenciálně diagnostickým znakem při odlišení ostatních Ph negativních CMPD, zejména esenciální trombocytemie.
Ve fibrotické fázi se v PK teprve postupně (nejčastěji až ve fázi MF-2) vyvíjí anemie, počet leukocytů může být snížený, normální i zvýšený. Je výrazná anizopoikilocytóza erytrocytů, typické jsou kapkovité erytrocyty, sférocyty, dále mohou být přítomny erytrocyty s Howellovými-Jollyho tělísky, bazofilním tečkováním, event. s Cabotovými prstenci a polychromazie. Typický je tzv. leukoerytroblas-
Tab. 1.5 Evropská klinická a patologická (ECP) kritéria pro diagnózu chronické idiopatické myelofibrózy (zdroj: Michiels, JJ., Kvasnicka, HM., Thiele, J. Myeloproliferative disorders. Current perspectives on diagnostic criteria, histopathology and treatment in essential trombocythemia, polycythemia rubra vera and chronic idiopathic myelofibrosis. Verlag ME – Uwe Grunwald, 2005)
KlinickákritériaHistologickákritéria
A1 bez diagnózy předcházejícího či současného dalšího subtypu CMPD včetně CML nebo MDS
C1 časné klinické stadium
Hb normální nebo mírná anemie grade I: Hb > 120 g/l mírná splenomegalie na ultrazvuku nebo CT trombocytóza > 400 × 109/l
C2 intermediární klinické stadium anemie grade II: Hb > 100 g/l leukoerytroblastický obraz a/nebo kapkovité erytrocyty splenomegalie
C3 pokročilé klinické stadium anemie grade III: Hb < 100 g/l splenomegalie trombocytopenie, leukocytóza nebo leukopenie
Diagnóza:
• •
megakaryocytární a granulocytární proliferace a relativní snížení erytropoezy abnormální shlukování a zmnožení atypických obrovských až středně velkých megakaryocytů s „obláčkovitými“ hypolobulovanými jádry a zřetelnou poruchou maturace
GradingmyelofibrózyuCIMF:
MF-0 prefibrotické stadium CIMF: bez retikulinové fibrotizace
MF-1 časná CIMF: mírná retikulinová fibrotizace
MF-2 manifestní CIMF: výrazná retikulinová a mírná kolagenní fibrotizace
MF-3 pokročilá CIMF: výrazná kolagenní fibrotizace +/osteoskleróza
Kombinace A1 + B1 odpovídá CIMF, každé další kritérium potvrzuje CIMF. C1 je obvykle spojeno s prefibrotickou (MF-0) nebo časnou fibrotickou (MF-1) CIMF. Hb – hemoglobin
Tab. 1.6 Hodnocení stupně fibrotizace v kostní d řeni – hodnocení se provádí pouze v buněčných (krvetvorných) úsecích d řeně (zdroj: Thiele, J., Kvasnicka, HM., Facchetti, F., et al. European consensus on grading bone marrow fibrosis and assessment of cellularity. Haematologica, 2005, 90, 8)
StupeňPopis
MF-0nečetná disperzní retikulinová vlákna
MF-1řídká síť retikulinových vláken, zejména perivaskulárně
MF-2difuzní a hustá síť retikulinových vláken, někdy s fokálními hrubými svazky kolagenu a/nebo fokální osteosklerózou
MF-3difuzní a hustá síť retikulinových vláken s hrubými svazky kolagenu, často spojená s výraznou osteosklerózou
tický obraz – jsou přítomny i méně zralé formy granulocytů včetně myeloblastů (pokud přesahují 10 %, jde již o akceleraci onemocnění a blížící se blastickou transformaci) i erytroidní prekurzory – erytroblasty. Počet trombocytů může být různý, v raně fibrotickém stadiu (MF-1, event. MF-2) je většinou ještě zvýšený, ve stadiích pokročilé myelofibrózy (typicky MF-3) bývá jejich počet snížený. Trombocyty jsou velmi různé co do velikosti, jsou přítomny také hypoaž agranulární formy, někdy bizarní a abnormálně velké útržky cytoplazmy megakaryocytů. Bývají nalezena také holá megakaryocytární jádra a mikromegakaryocyty. Dysgranulopoeza může být signálem progrese choroby. Skóre NAP bývá zvýšené.
Aspirát KD v této fázi bývá hypocelulární, často se jedná téměř úplně o periferní krev, mohou být zastiženy atypické megakaryocyty. Většinou však jde o „suchou“ punkci.
Histologie KD: Typickým histologickým nálezem ve fibrotické fázi je povšechný sklon k fibrotizaci dřeně, nejprve retikulinové jemné (časná CIMF, MF-1), postupně narůstající (plně rozvinutá CIMF, MF-2, 3) s ukládáním kolagenních vláken a osteoplazií až k obrazu osteomyelosklerózy. Zmnožuje se vaskularizace, nápadná je
intrasinusoidální hematopoeza v dilatovaných sinusoidách. Buněčnost postupně klesá, později jsou přítomny i okrsky zcela bez hematopoezy. Poměrně časté jsou drobné reaktivní nodulární infiltráty z malých lymfocytů, v těchto případech je však nutné odlišit autoimunitní formy myelofibrózy. Zmnožení a akumulace blastů naznačuje počínající transformaci procesu do obrazu akutní leukemie. Histologický nález může předcházet klinický obraz či cytologický průkaz transformace.
FCM: Nález v periferní krvi i kostní dřeni je u CIMF, stejně jako u jiných CMPD, necharakteristický. V časných fázích onemocnění je v PK prokazatelné zvýšení endoteliálních progenitorových buněk s imunofenotypem CD34+ CD133+ a VEGFR-2+ (vascular endothelial growth factor). Klinicky užitečné může být stanovení hematopoetických progenitorových buněk CD34+ v PK. V pokročilejších stadiích CIMF bývají (na rozdíl od ET) výrazně zmnožené jak relativně, tak i absolutně
Genetika: Více než třetina pacientů nese nespecifické cytogenetické abnormality jako del(13q), del(20q), +8, del(5q), parciální duplikaci 1q, -5, -7, +9 apod. Zhruba u poloviny pacientů je detekována mutace genu JAK2, v některých případech i homozygotní.
B1
1.6 Esenciální trombocytemie
(obr. 1.82–1.90)
Esenciální trombocytemie (ET) je klonální myeloproliferativní onemocnění charakterizované postižením megakaryopoezy se značnou trombocytemií v PK. Onemocnění striktně diagnostikované podle kritérií WHO (tab. 1.7), resp. ECP (tab. 1.8), nemá tendenci přecházet do myelofibrózy či sekundární AML. Nastane-li tato situace, jde spíše o efekt předchozí léčby cytostatiky.
V PK je značná trombocytemie – podle kritérií WHO > 600 × 109/l (podle kritérií ECP > 400 × 109/l), míra anizocytózy trombocytů (PDW) je velká, trombocyty bývají často hypo- či agranulární. Někdy je přítomna mírná neutrofilie. Může být zvýšené skóre alkalické fosfatázy v neutrofilech. U pacientů po infarzaci sleziny mohou být známky hyposplenismu – Howellova-Jollyho tělíska, bazofilní tečkování erytrocytů
Aspirát KD bývá normocelulární, s velkými shluky trombocytů a četnými megakaryocyty, většinou obrovskými až gigantickými, s hyperlobulovaným jádrem a s objemnou cytoplazmou. Častým nálezem je emperipoleza – přítomnost intaktních leukocytů či hematopoetických prekurzorů v cytoplazmě megakaryocytů. Malé formy megakaryocytů se u neléčených případů nenacházejí.
Histologie KD: Kostní dřeň je obvykle normocelulární nebo jen lehce hypercelulární (na rozdíl od nápadně buněčné prefibrotické nebo časné CIMF) s nápadnou megakaryocytární proliferací bez retikulinové fibrotizace. Velké megakaryocyty s extrémně (až „parohovitě“) členěným jádrem tvoří rozvolněné shluky (někdy se zastihnou dva velké megakaryocyty v pozici „líbajících se“ megakaryocytů) a jsou přítomny i peritrabekulárně. Malé megakaryocyty s hypolobulovanými a hyperchromními jádry či nukleocytoplazmatickou asynchronií typické pro
Tab. 1.7 Kritéria WHO pro esenciální trombocytemii
Pozitivníkritéria
1. Přetrvávající počet trombocytů > 600 × 109/l
CIMF nejsou přítomny, „dysplastické“ změny se objevují až v souvislosti s terapií. Léčbou ovlivněný terén neumožňuje jednoznačné rozlišení mezi jednotlivými typy myeloproliferací.
FCM: U esenciální trombocytemie nejsou přítomny žádné specifické imunofenotypové abnormality.
Genetika: 95 % pacientů má normální karyotyp, případné chromozomální aberace a genetické změny jsou podobné jako u PV. Asi u poloviny pacientů je detekována mutace genu JAK2 v heterozygotní formě
1.7 Chronické myeloproliferativní
onemocnění neklasifikovatelné
Jako chronické myeloproliferativní onemocnění neklasifikovatelné (CMPD,U) se označují pouze případy, kdy klinické, laboratorní a morfologické rysy svědčí pro myeloproliferativní onemocnění, avšak nesplňují kritéria pro žádnou ze specifických jednotek nebo jde o překryv („overlap“) dvou či více jednotek. Vždy musí být jednoznačně vyloučeny reaktivní stavy imitující chronické myeloproliferativní onemocnění. Většinou jde o ještě ne plně rozvinuté formy PV, CIMF či ET či naopak o pokročilá stadia CMPD, kdy myelofibróza, osteoskleróza nebo transformace do agresivnějšího stadia onemocnění nedovolují určit původní onemocnění.
Nikdy není přítomen Ph chromozom či BCR/ABL fúzní gen. Mutace genu JAK2 může být přítomna.
Naprostá většina případů s trombocytemií dříve nebo později splní kritéria CIMF podle WHO klasifikace. V některých případech může jít o histologicky nerozpoznanou prepolycytemickou fázi PV (ta je totiž definována pouze ECP kritérii, nikoliv WHO klasifikací).
2. Biopticky prokázaná proliferace především megakaryocytární řady se zvýšeným počtem obrovských zralých megakaryocytů
Kritériakvyloučení
1. Vyloučení PV:
– normální objem erytrocytární masy nebo hemoglobin < 185 g/l u mužů či < 165 g/l u žen – přítomnost barvitelného Fe v kostní dřeni, normální hladina sérového feritinu nebo normální MCV erytrocytů (při nesplnění tohoto kritéria, resp. sideropenie, musí být PV vyloučena negativním testem léčby železem – nedojde ke zvýšení RCM nebo hladiny hemoglobinu na hodnoty diagnostické pro PV)
2. Vyloučení CML:
– nepřítomnost BCR/ABL fúzního genu
3. Vyloučení chronické idiopatické myelofibrózy:
bez kolagenní fibrózy
žádná či jen minimální retikulinová fibróza
4. Vyloučení MDS: – nepřítomnost del(5q), t(3;3)(q21;q26), inv(3)(q21q26)
– nepřítomnost granulocytární dysplazie a žádné mikromegakaryocyty
5. Vyloučení reaktivní trombocytemie v souvislosti s: – probíhajícím zánětem nebo infekcí – malignitou
– předchozí splenektomií
MCV – průměrný objem (mean cell volume) erytrocytů; RCM – celková erytrocytární masa (red cell mass)
Tab. 1.8 Evropská klinická a patologická (ECP) kritéria pro diagnózu esenciální trombocytemie (zdroj: Michiels, JJ., Kvasnicka, HM., Thiele, J. Myeloproliferative disorders. Current perspectives on diagnostic criteria, histopathology and treatment in essential trombocythemia, polycythemia rubra vera and chronic idiopathic myelofibrosis. Verlag ME – Uwe Grunwald, 2005)
KlinickákritériaHistologickákritéria
A1 přetrvávající zvýšení počtu trombocytů nad 400 × 109/l
B1
A2 normální velikost sleziny nebo mírná splenomegalie zjištěná ultrazvukem
A3 normální nebo zvýšené skóre NAP a normální sedimentace erytrocytů
A4 spontánní tvorba megakaryocytárních kolonií (CFU-Meg) a/nebo erytroidních kolonií (EEC)
A5 vyloučení reaktivní trombocytózy
A6 vyloučení diagnózy předcházejícího nebo současného jiného typu CMPD včetně CML nebo MDS
A7 nepřítomnost Ph chromozomu nebo BCR-ABL fúzního genu
Diagnóza:
převažující proliferace disperzních nebo řídce se shlukujících zvětšených až obrovských megakaryocytů s hyperlobulovanými jádry a se zralou cytoplazmou, bez nápadnějších cytologických abnormalit bez známek proliferace granulopoezy či jejího posunu doleva bez známek proliferace erytropoezy
žádné nebo jen hraniční zmnožení retikulinu
A1 + B1 + B2 odpovídá ET. Jakékoli další kritérium A potvrzuje diagnózu ET. Grade I ET – počet trombocytů 400–1000 × 109/l; grade II ET – počet trombocytů 1000–1500 × 109/l; grade III ET – počet trombocytů > 1500 × 109/l
CFU-Meg – jednotka tvořící megakaryocytární kolonie (megakaryocytic colony-forming unit); EEC – endogenní tvorba erytroidních kolonií (endogenous erythroid colony formation)
B2
Obr. 1.1 Chronická myeloidní leukemie, chronická fáze; periferní krev. Výrazná leukocytóza, zastoupená r ůznými vývojovými stadii neutro fi lní granulopoezy, typické je výrazn ě jší zastoupení myelocytů a segmentů
Obr. 1.2 Chronická myeloidní leukemie, chronická fáze; periferní krev. Stejný p řípad jako obr. 1.1. Výrazná leukocytóza, zastoupeny jsou př edevším myelocyty, tyč e a segmenty, mén ě metamyelocyty, ojediněle promyelocyty č i myeloblast (v pravém horním kvadrantu). Granulocyty jsou morfologicky normální.
Obr. 1.3 Chronická myeloidní leukemie, chronická fáze; periferní krev. Stejný p ř ípad jako obr. 1.1 a 1.2. Jsou zastoupena všechna vývojová stadia neutro fi lní granulopoezy – v levém dolním rohu myeloblast, p ř i pravém okraji pod sebou sm ěrem ke stř edu obrázku jsou tř i promyelocyty, dále jsou p ř ítomny č etné myelocyty, tyč e, segmenty a méně metamyelocyty.
Obr. 1.4
Chronická myeloidní leukemie, chronická fáze; periferní krev, pr ůkaz alkalické fosfatázy v neutrofi lech. Pod stř edem obrázku je neutrofi l hodnocený semikvantitativně jako 1, ostatní neutrofi ly na obrázku jsou negativní. Skóre alkalické fosfatázy v neutrofilech je u CML v chronické fázi typicky snížené až nulové a je dáno pravd ě podobn ě snížením až vymizením aktivity tohoto enzymu. B ěhem p ř ípadných interkurentních infekcí a s akcelerací onemocn ění se skóre alkalické fosfatázy v neutrofi lech zvyšuje na normální hodnoty.
Obr. 1.5
Chronická myeloidní leukemie, chronická fáze; aspirát KD. Výrazně hypercelulární aspirát, s výraznou proliferací granulopoezy a megakaryopoezy. Megakaryocyty č asto bývají v koncích nátěru ve shlucích a jsou menší, s hypolobulovanými jádry.
Obr. 1.6
Chronická myeloidní leukemie, chronická fáze; aspirát KD. Výrazná proliferace neutrofi lní granulopoezy př i malém zvětšení, vlevo naho ř e a vpravo dole malé jednojaderné megakaryocyty.
Obr. 1.7 Chronická myeloidní leukemie, chronická fáze; aspirát KD. Stejný p ř ípad jako obr. 1.6. Krom ě proliferace neutro fi lní granulopoezy jsou zmnoženy také elementy eozinofi lní granulopoezy – na obrázku jsou č ty ř i eozinofi lní myelocyty a jeden metamyelocyt.
Obr. 1.8 Chronická myeloidní leukemie; aspirát KD. Relativn ě č astý je u CML nález st ř ádacích bun ě k, resp. makrofág ů. Na obrázku jsou t ř i pseudo-Gaucherovy bu ňky – makrofágy stř ádající zbytky bun ěk a lipidové inkluze, jako důsledek insu fi cience enzymatického systému degradujícího glukocerebrosidy p ř i zvýšeném bun ěč ném obratu. Typická je pro n ě p ř ítomnost zde modravých (jindy šedomodrých) fi brilárních struktur v cytoplazmě, jejichž dvojlom v polariza č ním světle je odlišuje od pravých Gaucherových buněk. V levém dolním rohu jsou velké modré inkluze, pocházející z rozpadlého sea-blue makrofágu – jiného typu stř ádacího makrofágu. St ř ádací bu ň ky nemají u CML (ani jiných CMPD) zvláštní diagnostický ani klinický význam. Uprostř ed je shluk promyelocytů
Obr. 1.9 Chronická myeloidní leukemie; aspirát KD. A: Naho ř e je pseudo-Gaucherova bu ňka, dole sea-blue makrofág s velkými modrými inkluzemi, mezi nimi menší megakaryocyt. B: Sea-blue makrofág s odlišnou morfologií – jasn ě modré inkluze jsou menší a splývající – cytoplazma se tak barví více homogenn ě
Obr. 1.10
Chronická myeloidní leukemie, chronická fáze; trepanobiopsie KD. Hypercelulární hematopoeza, obrazu dominuje vyzrávající granulocytární řada – granulocytární subtyp. Erytropoeza je minimáln ě zastoupená a je rozptýlená. Megakaryocyty nejsou přítomny. Bez výraznější fibrotizace či hemosiderózy.
Obr. 1.11
Chronická myeloidní leukemie, chronická fáze; trepanobiopsie KD, barvení podle Giemsy. Hypercelulární d ř e ň s p ř evahou hematopoezy nad tukovou tkání. P ř evaha vyzrávající granulocytární ř ady bez zmnožení blastů, zcela ne č etné disperzní erytroblasty.
Obr. 1.12
Chronická myeloidní leukemie, chronická fáze; trepanobiopsie KD. Megakaryocyty jsou v tomto p ř ípad ě siln ě zmnoženy a jeví tendenci ke shlukování – subtyp bohatý na megakaryocyty. Na rozdíl od ostatních myeloproliferací jsou buď poněkud menší, nebo p ř im ěř eného vzhledu, bez výrazn ějších „dysplastických“ rys ů
Obr. 1.13
Chronická myeloidní leukemie, chronická fáze; aspirát KD. St ř edn ě bun ěč né nátě ry se zmnožením megakaryopoezy. Megakaryocyty jsou č asto menší a mají hypolobulovaná jádra. Granulopoeza není zvýšen ě zastoupena. Jde o neobvyklý p ř ípad s normální hodnou WBC bez posunu doleva, s lehkou anemií a výraznou trombocytemií – 2400 × 10 9 /l, bez splenomegalie, BCR-ABL pozitivní. D ř íve se tyto jednotky ozna č ovaly jako Ph+ esenciální trombocytemie.
Obr. 1.14
Chronická myeloidní leukemie, chronická fáze; aspirát KD. Stejný p ř ípad jako obr. 1.13. Shluk šesti malých megakaryocyt ů s hypolobulovanými jádry, jejich morfologie je pro CML typická.
Obr. 1.15 Chronická myeloidní leukemie, chronická fáze; trepanobiopsie KD, imunohistologie. Stejný p ř ípad jako obr. 1.13 a 1.14. Zhruba normocelulární hematopoeza s extrémním zmnožením shlukujících se megakaryocytů – subtyp bohatý na megakaryocyty. Megakaryocyty zvýrazn ěné silnou cytoplazmatickou expresí CD61 jsou obvykle p ř im ěř en ě velké nebo menší, jádra mají hypolobulovaná, nepravidelná až oválná, většinou nikoli hyperchromní. Č ervená ř ada tvo ř í erytrony, granulocytární ř ada je vysloven ě nenápadná, vyzrává, bez zmnožení blastů. Fibrotizace nebyla prokázána.
Obr. 1.16
Chronická myeloidní leukemie, akcelerovaná fáze; periferní krev. Bazofi lie – na obrázku je devět bazofilů – osm segmentů a uprostř ed pravděpodobně bazo fi lní metamyelocyt. Bazo fi lní segment vlevo je hyperdiploidní. Lehká anizocytóza erytrocytů
Obr. 1.17
Chronická myeloidní leukemie, akcelerovaná fáze; aspirát KD. Zmnožení myeloblastů – na obrázku jsou č ty ř i, ten horní z dvojice v levé polovině obrázku má v cytoplazm ě hrubší azurofi lní granula. Mimo n ě jsou na obrázku zralejší elementy neutrofi lní granulopoezy, t ř i monocyty (vlevo naho ř e dva a napravo od středu pod velkým myeloblastem jeden). Naho ř e uprost ř ed je bazo fi lní segment s č áste č n ě v.s. arteficiálně lyzovanými granuly, dále jsou zde tř i erytroblasty (dva bazofi lní a jeden pozdní polychromatofi lní) s mírně atypickými tvary jader.

Obr. 1.18 Chronická myeloidní leukemie, akcelerovaná fáze; aspirát KD. V levém horním kvadrantu je naho ř e atypický neutro fi l s hrubými granuly v cytoplazm ě a pod ním dva velké blasty III. typu (s č etnými jemnými granuly, na pomezí myeloblastu a promyelocytu) s nepravidelným tvarem jádra a s vakuolizací cytoplazmy. V levém dolním kvadrantu jsou dva blasty – ten vlevo obrovský, s nepravidelným tvarem jádra a vakuolizací cytoplazmy i jádra, ten vpravo s bazo fi lními granuly. Mezi nimi je naho ř e mladý element monocytoidní morfologie s drobnými protruzemi jádra a pod ním velmi mladý element č ervené ř ady – ve stadiu na pomezí proerytroblastu a bazo fi lního erytroblastu. V pravé polovin ě obrázku je blast, č áste č n ě degranulovaný eozino fi lní metamyelocyt, neutrofi lní segment s vakuolizací cytoplazmy a pozdní polychromato fi lní erytroblast s atypickým tvarem jádra. Mimo to jsou na obrázku dvě rozpadající se holá jádra a dole rozpadající se bazofi l.




Obr. 1.19 Chronická myeloidní leukemie, akcelerovaná fáze; aspirát KD. Stejný p ř ípad jako obr. 1.18. V levém horním kvadrantu je atypický promyelomonocytoidní element a zralý eozino fi l, v levém dolním kvadrantu dysplastický neutrofilní metamyelocyt s atypickým tvarem jádra a hypogranulární cytoplazmou, neutrofi lní segment a bazo fi lní erytroblast s nepravidelnostmi jaderné membrány, pravd ě podobně v profázi. Nahoř e uprostř ed je bazofi lní myelocyt, pod ním tém ěř degranulovaný bazofi lní segment. V pravém horním kvadrantu je eozinofi lní a bazo fi lní segment a dva č asné polychromato fi lní erytroblasty s mírn ě nepravidelnými tvary jádra, v pravém dolním kvadrantu je dysplastický neutro fi lní metamyelocyt s protruzemi jaderné hmoty, blastický element s bazo fi lními granuly a vakuolizací a hypersegmentovaný neutro fi l s vakuolizací. Dysplastické zm ě ny souvisejí nejen s progresí samotné choroby, ale také s p ř edchozí cytotoxickou terapií.
Obr. 1.20 Chronická myeloidní leukemie, akcelerovaná fáze; aspirát KD. Stejný p ř ípad jako obr. 1.18 a 1.19. Zmnožení většinou těžce abnormálních eozinofi lů – na obrázku jsou č ty ř i: degranulace, vakuolizace cytoplazmy, perzistence tmav ě purpurových proeozinofi lních granul. Dále jsou z ř etelné neutrofi lní segment, č asný polychromatofi lní erytroblast s jaderným fragmentem, č asný polychromato fi lní megaloblast a atypický bazofi l.
Obr. 1.21 Chronická myeloidní leukemie, myeloidní blastický zvrat; periferní krev. Leukocytóza daná p ř ítomností blastů – ty mají v tomto případě nepravidelný tvar jádra s jedním č i více nukleoly a světle bazofi lní agranulární cytoplazmu. Blast dole uprostř ed má č etné protruze jaderné hmoty do cytoplazmy. Myeloidní pů vod blastů byl prokázán imunofenotypizací. Dále jsou na obrázku dv ě neutro fi lní ty č e, anizocytóza a poikilocytóza erytrocytů